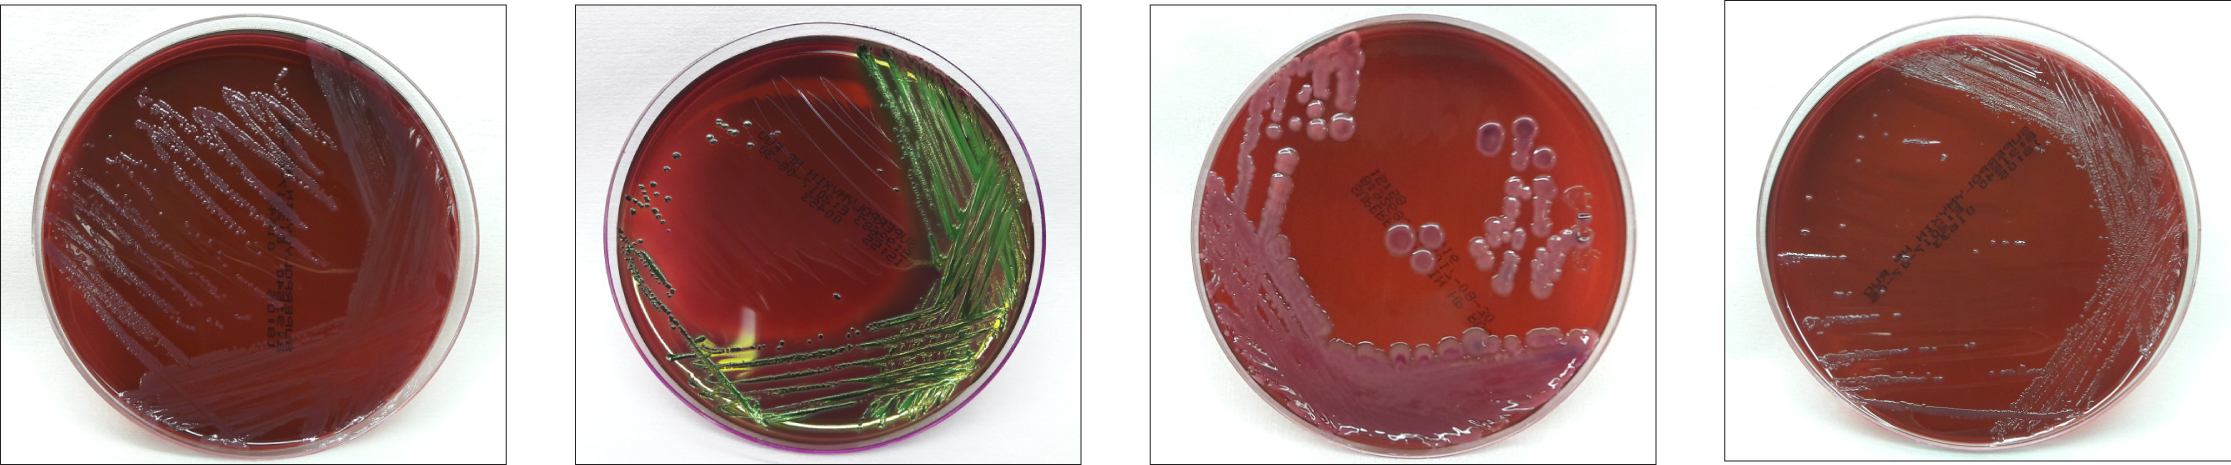
polimixine 2

Η πολυμυξίνη Β είναι ένα αντιβιοτικό
Η πολυμυξίνη Β είναι ένα αντιβιοτικό που χρησιμοποιείται, κυρίως, για ανθεκτικές Gram αρνητικές λοιμώξεις.
Η πολυμυξίνη Β (polymyxin B) έχει βακτηριοκτόνο δράση κατά σχεδόν όλων των Gram-αρνητικών βακτηρίων, εκτός από την ομάδα Proteus.
Η πολυμυξίνη Β αλληλεπιδρά με το λιποπολυσακχαρίτη της εξωτερικής μεμβράνης των Gram-αρνητικών βακτηρίων, μεταβάλλοντας την διαπερατότητα της μεμβράνης και προκαλώντας κυτταρικό θάνατο.
Η πολυμυξίνη παρεμποδίζει το σχηματισμό της βιταμίνης Κ από τα εντερικά βακτήρια.
Η πολυμυξίνη Β είναι ένα αντιβιοτικό που προέρχεται από το βακτήριο Bacillus polymyxa.
Έχει βακτηριοκτόνο δράση ενάντια σε όλους σχεδόν τους Gram-αρνητικούς βακίλους εκτός από τα γένη Proteus και Neisseria.
Οι πολυμυξίνες δεσμεύονται στην κυτταρική μεμβράνη και μεταβάλλουν τη δομή της, καθιστώντας την πιο διαπερατή. Η απορρόφηση νερού που προκύπτει οδηγεί σε κυτταρικό θάνατο. Οι πολυμυξίνες είναι κατιονικά, βασικά πεπτίδια που δρουν σαν απορρυπαντικά (τασιενεργά).
Οι παρενέργειες περιλαμβάνουν νευροτοξικότητα και οξεία νεφρική σωληναριακή νέκρωση.
Οι πολυμυξίνες χρησιμοποιούνται στο τοπικό παρασκεύασμα Neosporin.
Η πολυμυξίνη μεταβάλλει τη διαπερατότητα της βακτηριακής εξωτερικής μεμβράνης με δέσμευση σε μια αρνητικά φορτισμένη θέση στο στρώμα λιποπολυσακχαριτών, η οποία έχει ηλεκτροστατική έλξη για τις θετικά φορτισμένες αμινομάδες στο τμήμα κυκλικού πεπτιδίου (αυτή η θέση κανονικά είναι μια θέση πρόσδεσης για τα ιόντα αντίθεσης ασβεστίου και μαγνησίου). Το αποτέλεσμα είναι μια αποσταθεροποιημένη εξωτερική μεμβράνη.
Το τμήμα των λιπαρών οξέων διαλύεται στην υδρόφοβη περιοχή της κυτταροπλασματικής μεμβράνης και διακόπτει την ακεραιότητα της μεμβράνης.
Υπάρχει διαρροή κυτταρικών μορίων και αναστολή της κυτταρικής αναπνοής.
Δεσμεύει και απενεργοποιεί την ενδοτοξίνη.
Η πολυμυξίνη Β αποτελείται από πολυμυξίνες Β1, Β1-Ι, Β2, Β3 και Β6. Οι πολυμυξίνες Β1 και Β2 θεωρούνται κύρια συστατικά. Αυτά τα σχετικά συστατικά είναι δομικά πανομοιότυπα με την εξαίρεση μιας ομάδας μεταβλητών λιπαρών οξέων σε κάθε κλάσμα.
Η πολυμυξίνη Β χρησιμοποιείται για τη θεραπεία λοιμώξεων της ουροποιητικής οδού και της μηνιγγίτιδας που προκαλούνται από την Pseudomonas aeruginosa και τον Haemophilus influenzae, αντίστοιχα.
Δεδομένα ευαισθησίας MIC-minimum inhibitory concentration για αυτούς τους μικροοργανισμούς.
Haemophilus influenzae: ≥ 0,8 μg / ml
Pseudomonas aeruginosa: 0,25 μg / ml – 1 μg / ml
Τα καλύτερα προϊόντα για τις λοιμώξεις
Πατήστε, εδώ, για να παραγγείλετε τα καλύτερα προϊόντα για τις λοιμώξεις
Η καθοδήγηση για την επιλογή των ποιων συμπληρωμάτων διατροφής, από τα ανωτέρω, είναι κατάλληλα για την ασθένειά σας θα γίνει σε συνεννόηση με τον θεράποντα ιατρό.
Διαβάστε, επίσης,
Χρήσιμες συμβουλές για το αντιγριπικό εμβόλιο
Εμβόλιο ιλαράς-παρωτίτιδας-ερυθράς